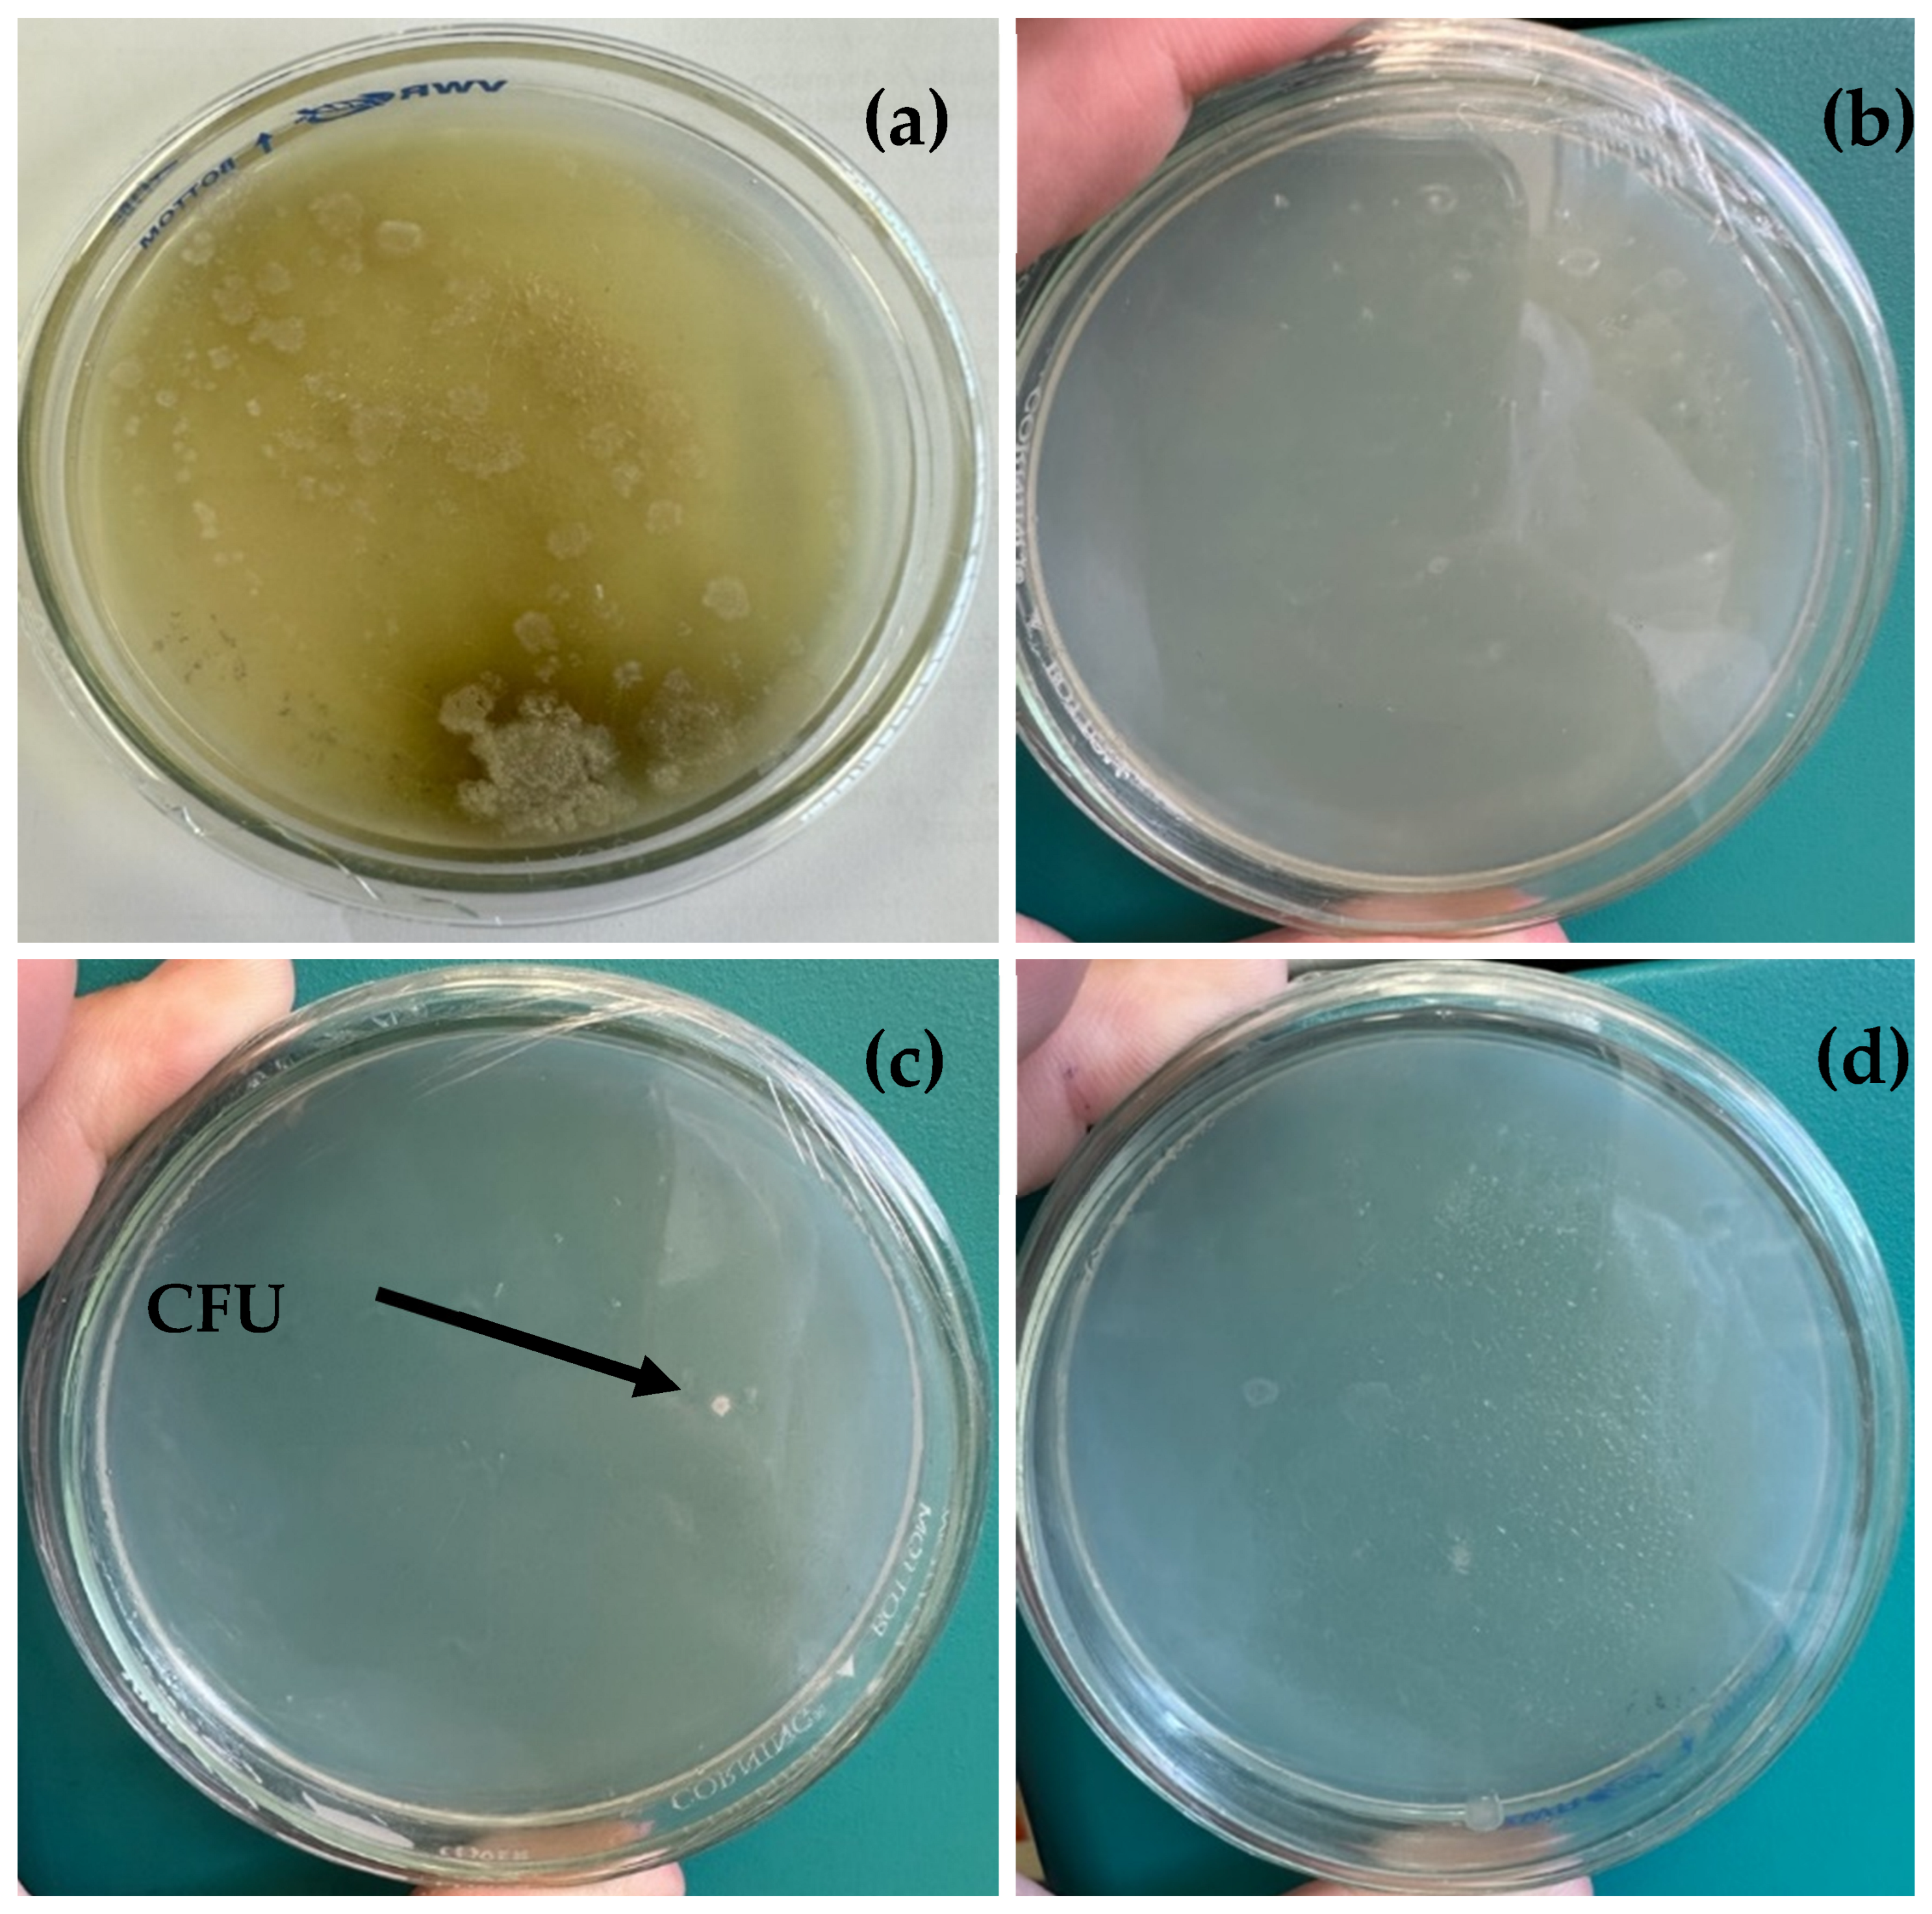
Applbiosci 04 00039 g007

Comparison of Susceptibility to Microbiological Contamination in FAMEs Synthesized from Residual and Refined Lard During Simulated Storage
Abstract
1. Introduction
2. Materials and Methods
2.1. Reagents
2.2. Materials
2.3. FAME Synthesis
2.4. FAME Purification
2.5. Samples and Microbiological Isolation
2.6. MALDI-TOF MS Assay
3. Results
3.1. FAME Synthesis and Purification
3.2. Microbial Profiles of Collected Samples
3.3. MALDI-TOF MS Analysis
4. Discussion
5. Conclusions
Author Contributions
Funding
Institutional Review Board Statement
Informed Consent Statement
Data Availability Statement
Acknowledgments
Conflicts of Interest
Abbreviations
| ASTM | American Society for Testing and Materials |
| B20 | Biodiesel 20% and petrodiésel 80% mix |
| TBHQ | Tert-butyl hydroquinone |
| CFU | Colony-Forming Unit |
| FAME | Fatty Acid Methyl Ester |
| MBO | 3,3-Methylenebis (5-methyloxazolidine) |
| MALDI TOF | Matrix-Assisted Laser Desorption/Ionization Time of Flight |
| MIT/CMIT | 5-Chloro-2-methyl-4-isothiazolin-3-one + 2-Methylisothiazol3(2H)-one |
| MS | Mass Spectrometry |
References
- Elgharbawy, A.S.; Wagih, A.S.; Sadek, O.M.; Kasaby, M.A. A review on biodiesel feedstocks and production technologies. J. Chil. Chem. Soc. 2021, 66, 5098–5109. [Google Scholar] [CrossRef]
- Praveena, V.; Martin, L.J.; Matijošius, J.; Aloui, F.; Pugazhendhi, A.; Varuvel, E.G. A systematic review on biofuel production and utilization from algae and waste feedstocks—A circular economy approach. Renew. Sust. Energ. Rev. 2024, 192, 114178. [Google Scholar] [CrossRef]
- Cerón Ferrusca, M.; Romero, R.; Martínez, S.L.; Ramírez-Serrano, A.; Natividad, R. Biodiesel production from waste cooking oil: A perspective on catalytic processes. Processes 2023, 11, 1952. [Google Scholar] [CrossRef]
- Srivastava, N.; Kharwar, R.K.; Mishra, P.K. Cost economy analysis of biomass-based biofuel production. In From Cellulose to Cellulase: Strategies to Improve Biofuel Production; Elsevier: Amsterdam, The Netherlands, 2019; pp. 1–10. [Google Scholar]
- Nurul Syahirah, M.A.; Shiong Khoo, K.; Wayne Chew, K.; Loke Show, P.; Chen, W.; Phong Nguyen, T.H. Sustainability of the four generations of biofuels—A review. Int. J. Energy Res. 2020, 44, 9266–9282. [Google Scholar]
- Khezerlou, A.; Akhlaghi, A.; Alizadeh, A.; Dehghan, P.; Maleki, P. Alarming impact of the excessive use of tert-butylhydroquinone in food products: A narrative review. Toxicol. Rep. 2022, 9, 1066–1075. [Google Scholar] [CrossRef]
- Xu, X.; Bi, Y.; Wang, H.; Li, J.; Xu, Z. Transformation of TBHQ in lard and soybean oils during room temperature. Eur. J. Lipid. Sci. Technol. 2019, 121, 1–8. [Google Scholar] [CrossRef]
- Shahabadi, N.; Maghsudi, M.; Kiani, Z.; Pourfoulad, M. Multispectroscopic studies on the interaction of 2-tert-butylhydroquinone (TBHQ), a food additive, with bovine serum albumin. Food Chem. 2010, 124, 1063–1068. [Google Scholar] [CrossRef]
- Jeyanthi, V.; Velusamy, P.; Kumar, G.V.; Kiruba, K. Effect of naturally isolated hydroquinone in disturbing the cell membrane integrity of Pseudomonas aeruginosa MTCC 741 and Staphylococcus aureus MTCC 740. Heliyon 2021, 7, e07021. [Google Scholar] [CrossRef]
- Menzes, L.N.B.; Suarez, P.A.A.; Ghesti, G.F. Diesel-like biofuels production using fatty waste. J. Braz. Chem. Soc. 2022, 33, 550–555. [Google Scholar] [CrossRef]
- Kusum, A.S.; Pour-Ghaz, M.; Ducoste, J.J. Reducing Fat, Oil, and Grease (FOG) deposits formation and adhesion on sewer collection system structures through the use of fly ash replaced cement-based materials. Water Res. 2020, 186, 116304. [Google Scholar] [CrossRef]
- Toldrá-Reig, F.; Mora, L.; Toldrá, F. Trends in biodiesel production from animal fat waste. Appl. Sci. 2020, 10, 3644. [Google Scholar] [CrossRef]
- Abdurrojaq, N.; Nulhakim, L.; Zaelani, R.; Ginanjar, K.; Riesta, A.; Lies, A.; Nur Allif, F.; Wibowo, C.S. Assessing water affinity properties of biodiesel, diesel fuel, and blends by measuring water saturation and water absorption. Int. Conf. Biomass Bioenergy 2022, 1187, 012042. [Google Scholar] [CrossRef]
- Komariah, L.N.; Arita, S.; Rendana, M.; Ramayanti, C.; Suriani, N.L.; Erisna, D. Microbial contamination of diesel-biodiesel blends in storage tank; an analysis of colony morphology. Heliyon 2022, 8, e09264. [Google Scholar] [CrossRef] [PubMed]
- Hosseinzadeh-Bandbafha, H.; Kumar, D.; Singh, B.; Shahbeiga, H.; Shiung Lam, S.; Aghbashlo, M.; Tabatabaei, M. Biodiesel antioxidants and their impact on the behavior of diesel engines: A comprehensive review. Fuel Process. Technol. 2022, 232, 107264. [Google Scholar] [CrossRef]
- Varatharajan, K.; Pushparani, D.S. Screening of antioxidant additives for biodiesel fuels. Renew. Sustain. Energy Rev. 2017, 82, 2017–2028. [Google Scholar] [CrossRef]
- Parawira, W. Biodiesel production from Jatropha curcas: A review. Sci. Res. Essays 2010, 5, 1796–1808. [Google Scholar]
- Bashir, M.A.; Wu, S.; Zhu, J.; Krosuri, A.; Khan, M.U.; Ndeddy Aka, R.J. Recent development of advanced processing technologies for biodiesel production: A critical review. Fuel Process. Technol. 2021, 227, 107120. [Google Scholar] [CrossRef]
- Catarino, M.; Ferreira, E.; Soares Dias, A.P.; Gomes, J. Dry washing Biodiesel Purification Using Fumed Silica Sorbent. J. Chem. Eng. 2019, 386, 123930. [Google Scholar] [CrossRef]
- ASTM D6751; Standard Specification for Biodiesel Fuel Blend Stock (B100) for Middle Distillate Fuels. ASTM International: West Conshohocken, PA, USA, 2009.
- ASTM E1259; Standard Practice for Evaluation of Antimicrobials in Liquid Fuels Boiling Below 390 °C. ASTM International: West Conshohocken, PA, USA, 2018.
- Ferreira, L.; Vega, S.; Sánchez-Juanes, F.; González, M.; Herrero, A.; Muñíz, M.C.; González-Buitrago, J.M.; Muñoz, J.L. Identificación bacteriana mediante espectrometría de masas matrix-assisted laser desorption ionization time-of-flight. Comparación con la metodología habitual en los laboratorios de Microbiología Clínica. Enferm. Infecc. Microbiol. 2009, 28, 492–497. [Google Scholar] [CrossRef]
- Zhang, Y.; Li, X.; Wang, Z.; Liu, H. Determination of biodiesel yield and color after purification process using deep eutectic solvent. Biomass Convers. Biorefin. 2022, 14, 1234–1245. [Google Scholar]
- Food and Agriculture Organization of the United Nations; World Health Organization. Codex Alimentarius; Food and Agriculture Organization of the United Nations: Rome, Italy; World Health Organization: Geneva, Switzerland, 2024. [Google Scholar]
- Banković-Ilić, I.B.; Stojković, I.J.; Stamenković, O.S.; Veljkovic, V.B.; Hung, Y. Waste animal fats as feedstocks for biodiesel production. Renew. Sust. Energ. Rev. 2014, 32, 238–254. [Google Scholar] [CrossRef]
- Felix-Uchenna, S.; Oluwoye, J. Good Practices and Principles in Pig Farming. In Production of Biofuel from Pork Fat, 1st ed.; Tanmoy, R., Soto-Blanco, B., Eds.; Springer: Berlin/Heidelberg, Germany, 2024; pp. 141–169. [Google Scholar]
- Bhattacharya, I.; Yan, S.; Tyagi, R.D.; Surampalli, R.; Zhang, T.C. Animal Fat Biodiesel; SAHVA: Brøndby, Denmark, 2019; pp. 123–149. [Google Scholar]
- Fregolente, P.B.; Wolf, M.R.; Oliveira, L.S. Removal of water content from biodiesel and diesel fuel using hydrogel adsorbents. Braz. J. Chem. Eng. 2015, 32, 895–901. [Google Scholar] [CrossRef]
- ASTM D2709; Standard Test Method for Water and Sediment in Middle Distillate Fuels by Centrifuge. ASTM International: West Conshohocken, PA, USA, 2022.
- Klofutar, B.; Golob, J. Microorganisms in Diesel and in Biodiesel Fuels. Acta. Chim. Slov. 2007, 54, 744–748. [Google Scholar]
- Bücker, F.; Santos Barbosa, C.; Dörr Quadros, P.; Krüger Bueno, M.; Fiori, P.; Huang, C.T.; Guedes Frazzon, A.P.; Flores Ferrão, M.; de Oliveira Camargo, F.A.; Menezes Bento, F. Fuel biodegradation and molecular characterization of microbial biofilms in stored diesel/biodiesel blend B10 and the effect of biocide. Int. Biodeter. Biodegr. 2014, 95, 346–355. [Google Scholar] [CrossRef]
- Koichi Harazono, K.; Atsumi, Y.; Shirasaka, N. Safety evaluation of collagenase from Streptomyces violaceoruber. Regul. Toxicol. Pharmacol. 2020, 113, 104645. [Google Scholar] [CrossRef] [PubMed]
- Eileen, F.; Dunne, E.F.; Burman, W.J.; Wilson, M.L. Streptomyces pneumonia in a patien with Human Immunodeficiency Virus Infection: Case report and review of the literature on invasive Streptomyces infections. Clin. Infect. 1998, 27, 93–96. [Google Scholar]
- Michel-Briand, Y.; Baysse, C. The pyocins of Pseudomonas aeruginosa. Biochimie 2002, 84, 499–510. [Google Scholar] [CrossRef]
- Passman, F.J. Microbial contamination and its control in fuels and fuel systems since 1980—A review. Int. Biodeter. Biodegr. 2013, 81, 88–104. [Google Scholar] [CrossRef]
- Chen, Y.; Liu, P.G.; Whang, L.; Wu, Y.; Cheng, S. Biodegradability and microbial community investigation for soil contaminated with diesel blending with biodiesel. Process Saf. Environ. 2019, 130, 115–125. [Google Scholar] [CrossRef]
- Bücker, F.; de Moura, T.M.; Espinosa da Cunha, M.; de Quadros, P.D.; Anderson Beker, S.; Juciana Clarice Cazarolli, J.C.; Bastos Caramão, E.; Guedes Frazzon, A.P.; Menezes Bento, F. Evaluation of the deteriogenic microbial community using qPCR, n-alkanes and FAMEs biodegradation in diesel, biodiesel and blends (B5, B10, and B50) during storage. Fuel 2017, 233, 911–917. [Google Scholar] [CrossRef]
- Lutz, G.; Chavarría, M.; Arias, M.L.; Mata-Segreda, J.F. Microbial degradation of palm (Elaeis guineensis) biodiesel. Rev. Biol. Trop. 2006, 54, 59–63. [Google Scholar] [CrossRef]
- Clarice Cazarolli, J.; Dörr Quadros, P.; Bücker, F.; Ruiz Frazão Santiago, M.; Sartori Piatnicki, M.; do Carmo Ruaro Peralba, M.; de Siqueira Cavalcanti, E.H.; Menezes Bento, F. Microbial growth in Acrocomia aculeata pulp oil, Jatropha curcas oil, and their respective biodiesels under simulated storage conditions. Biofuel. Res. J. 2016, 3, 514–520. [Google Scholar] [CrossRef][Green Version]
- Livramento Silva, T.; Clarice Cazarolli, J.; Mara Pizzolato, T.; Guedes Frazzon, A.P.; Bertori Mann, M.; Frazzon, J.; Kochenborger John, D.; Ferrão Flôres, M.; Rampelotto, P.H.; Bezerra D’ Alessandro, E.; et al. Microbial sludge formation in Brazilian marine diesel oil (B0) and soybean methylic biodiesel blends (B10 and B20) during simulated storage. Fuel 2021, 308, 121905. [Google Scholar] [CrossRef]
- Al-Dhabaan, F.A. Dissolution of clotted blood from slaughtered cattle by alkaline protease produced by Streptomyces violaceoruber isolated from saline soil in Saudi Arabia. J. King Saud Univ. Sci. 2024, 36, 103300. [Google Scholar] [CrossRef]
- Khuran, S.; Kapoor, M.; Gupta, S.; Kuhad, R.C. Statistical optimization of alkaline xylanase production from Streptomces violaceoruber under submerged fermentation using response surface methodology. Indian J. Microbiol. 2007, 47, 144–152. [Google Scholar] [CrossRef]
- Schmidt, K.; Spiteller, D. Ammonia Released by Streptomyces aburaviensis Induces Droplet Formation in Streptomyces violaceoruber. J. Chem. Ecol. 2017, 43, 806–816. [Google Scholar] [CrossRef]
- Thomas, O.A.; Leahy, C.M.; Smith, W.N.J.; Spence, J.M. Natural attenuation of fatty acid methyl esters (FAME) in soil and groundwater. Q. J. Eng. Geol. Hydrogeol. 2017, 50, 301–317. [Google Scholar] [CrossRef]
- Soriano Ururahy, A.; Martins, L.F.; de Assumpção Ventura, E.S.; Gerken de Landa, F.H.T.; de Araújo Valoni, É.; Dutra Faria, F.R.; Fragoso Ferreira, R.; Kremer Faller, M.C.; Rocha Valerio, R.; de Assis Leite, D.C.; et al. Microbiological aspects of biodiesel and biodiesel/diesel blends biodeterioration. Int. Biodeterior. Biodegrad. 2015, 99, 102–114. [Google Scholar] [CrossRef]
- Schleicher, T.; Werkmeister, R.; Russ, W.; Meyer-Pittroff, R. Microbiological stability of biodiesel–diesel-mixtures. Bioresour. Technol. 2008, 100, 724–730. [Google Scholar] [CrossRef]
- Zimmer, A.; Cazarolli, J.; Teixeira, R.M.; Viscardi, S.L.C.; Cavalcanti, E.S.H.; Gerbase, A.E.; Ferrão, M.F.; Piatnicki, C.M.S.; Bento, F.M. Monitoring of efficacy of antimicrobial products during 60 days storage simulation of diesel (B0), biodiesel (B100) and blends (B7 and B10). Fuel 2013, 112, 153–162. [Google Scholar] [CrossRef]

| Microorganism | FAMEs Raw Material | Interaction of Microorganism with FAME | Ref. |
|---|---|---|---|
| Pseudomonas aeruginosa | Residual vegetable oil | The impact of Pseudomonas aeruginosa on FAME is mainly related to its ability to cause biodeterioration. These bacteria can contribute to biofilm formation and degradation of FAME components, which can result in decreased fuel quality and operational problems, such as filter plugging. | [35,36] |
| 90% soy, 10% tallow | The impact of Pseudomonas aeruginosa on FAME is mainly related to its ability to degrade compounds present in this type of fuel. This bacteria can contribute to the biodegradation of FAMEs, affecting its quality and stability during storage. | [37] | |
| 80% soy, 20% tallow | Pseudomonas is one of the principal fuel-biodeteriorating contaminants, together with Comamonas, Burkholderia, Klebsiella, Tolumonas, Candida, Aspergillus, Fusarium. | [28] | |
| Palm oil | Palm oil and FAMEs are subjected to aerobic biodegradation by bacteria like Pseudomonas, commonly present in natural open environments. | [38] | |
| J. curcas A. aculeata | The FAMEs exhibited noticeable deterioration by Pseudomonas during simulated storage conditions, primarily due to microbial contamination. Significant shifts in pH, surface tension, and ester content were observed even over a short 30-day period, with fungal inoculation accelerating the degradation process resulting in up to a 12% reduction in ester concentration. | [39] | |
| Soy oil (B20) | The addition of FAMEs leads to an increase in the number of microorganisms, resulting in the degradation of the fraction corresponding to FAMEs producing aldehydes and ketones. | [40] | |
| Streptomyces violaceoruber | In the present work, this microorganism was identified in the FAME of residual lard, not previously reported by scientific literature. However, this microorganism is very commonly found in various places such as soil [41], industry [42], and water [43]. | ||
Disclaimer/Publisher’s Note: The statements, opinions and data contained in all publications are solely those of the individual author(s) and contributor(s) and not of MDPI and/or the editor(s). MDPI and/or the editor(s) disclaim responsibility for any injury to people or property resulting from any ideas, methods, instructions or products referred to in the content. |
© 2025 by the authors. Licensee MDPI, Basel, Switzerland. This article is an open access article distributed under the terms and conditions of the Creative Commons Attribution (CC BY) license (https://creativecommons.org/licenses/by/4.0/).
Share and Cite
Lepe-de-Alba, S.; Garcia-Gonzalez, C.; Solis-Dominguez, F.A.; Martínez-Miranda, R.; Carrillo-Beltrán, M.; Arcos-Vega, J.L.; Sagaste-Bernal, C.A.; Pérez-Sánchez, A.; Coronado-Ortega, M.A.; Ayala-Bautista, J.R. Comparison of Susceptibility to Microbiological Contamination in FAMEs Synthesized from Residual and Refined Lard During Simulated Storage. Appl. Biosci. 2025, 4, 39. https://doi.org/10.3390/applbiosci4030039
Lepe-de-Alba S, Garcia-Gonzalez C, Solis-Dominguez FA, Martínez-Miranda R, Carrillo-Beltrán M, Arcos-Vega JL, Sagaste-Bernal CA, Pérez-Sánchez A, Coronado-Ortega MA, Ayala-Bautista JR. Comparison of Susceptibility to Microbiological Contamination in FAMEs Synthesized from Residual and Refined Lard During Simulated Storage. Applied Biosciences. 2025; 4(3):39. https://doi.org/10.3390/applbiosci4030039
Chicago/Turabian StyleLepe-de-Alba, Samuel, Conrado Garcia-Gonzalez, Fernando A. Solis-Dominguez, Rafael Martínez-Miranda, Mónica Carrillo-Beltrán, José L. Arcos-Vega, Carlos A. Sagaste-Bernal, Armando Pérez-Sánchez, Marcos A. Coronado-Ortega, and José R. Ayala-Bautista. 2025. "Comparison of Susceptibility to Microbiological Contamination in FAMEs Synthesized from Residual and Refined Lard During Simulated Storage" Applied Biosciences 4, no. 3: 39. https://doi.org/10.3390/applbiosci4030039
APA StyleLepe-de-Alba, S., Garcia-Gonzalez, C., Solis-Dominguez, F. A., Martínez-Miranda, R., Carrillo-Beltrán, M., Arcos-Vega, J. L., Sagaste-Bernal, C. A., Pérez-Sánchez, A., Coronado-Ortega, M. A., & Ayala-Bautista, J. R. (2025). Comparison of Susceptibility to Microbiological Contamination in FAMEs Synthesized from Residual and Refined Lard During Simulated Storage. Applied Biosciences, 4(3), 39. https://doi.org/10.3390/applbiosci4030039

